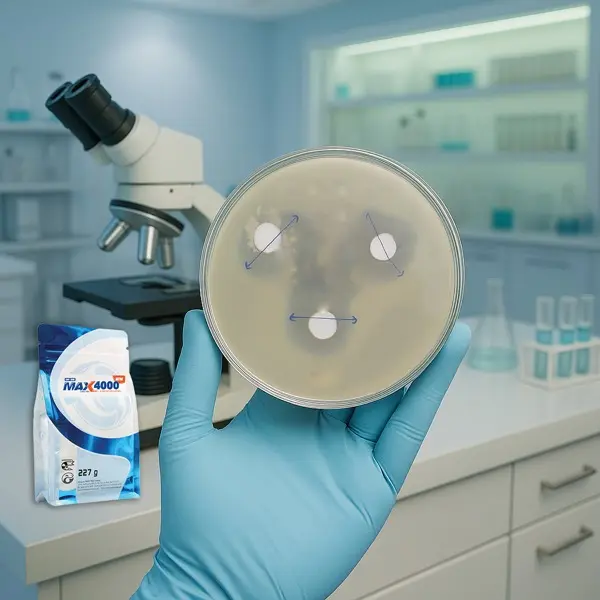
VI SINH KHÁNG VIBRIO ĐỘC LỰC CAO

Ao của bạn đang ở giai đoạn nào? — phác đồ chữa khi đã có vấn đề
Chọn dấu hiệu — nhận phác đồ xử lý có sẵn từ kỹ thuật Thần Vương.
Bài nổi bật
Một số bài đọc kỹ thuật tiêu biểu.
Bốn điểm vào nhanh vào thư viện đang hoạt động.
Kiến thức theo loài
Kiến thức theo loài nuôi
Xem toàn bộ bài viết
Toàn bộ bài kỹ thuật
247 kết quả
 TÔM 54 NGÀY - 69 CON/KG, GIẢM 25% NƯỚC THAY
TÔM 54 NGÀY - 69 CON/KG, GIẢM 25% NƯỚC THAY Toàn cảnh thị trường tôm thế giới 2025 — Dữ liệu từ Shrimp Insights (Tháng 2/2026)
Toàn cảnh thị trường tôm thế giới 2025 — Dữ liệu từ Shrimp Insights (Tháng 2/2026) SỰ THAY ĐỔI CỦA HỆ VI SINH ĐƯỜNG RUỘT DO SỰ NÓNG LÊN TOÀN CẦU. ĐIỀU HÒA SỨC KHỎE VẬT CHỦ VÀ TÌNH TRẠNG BỆNH Ở ĐỘNG VẬT BIẾN NHIỆT
SỰ THAY ĐỔI CỦA HỆ VI SINH ĐƯỜNG RUỘT DO SỰ NÓNG LÊN TOÀN CẦU. ĐIỀU HÒA SỨC KHỎE VẬT CHỦ VÀ TÌNH TRẠNG BỆNH Ở ĐỘNG VẬT BIẾN NHIỆT CÁ HỒI TRONG ĐIỀU KIỆN STRESS: CỦNG CỐ TUYẾN PHÒNG THỦ ĐẦU TIÊN
CÁ HỒI TRONG ĐIỀU KIỆN STRESS: CỦNG CỐ TUYẾN PHÒNG THỦ ĐẦU TIÊN Giảm Thiểu Rủi Ro Nằm Ở Tư Duy Quản Trị Hệ Thống
Giảm Thiểu Rủi Ro Nằm Ở Tư Duy Quản Trị Hệ Thống PHÁC ĐỒ ĐIỀU TRỊ BỆNH VÀNG MIỆNG TRÊN TÔM THẺ CHÂN TRẮNG
PHÁC ĐỒ ĐIỀU TRỊ BỆNH VÀNG MIỆNG TRÊN TÔM THẺ CHÂN TRẮNG QUẢN LÝ THỨC ĂN TÔM TRONG AO NGOÀI TRỜI ĐỐI VỚI TÔM THẺ CHÂN TRẮNG
QUẢN LÝ THỨC ĂN TÔM TRONG AO NGOÀI TRỜI ĐỐI VỚI TÔM THẺ CHÂN TRẮNG PHÂN TÍCH HỆ PHIÊN MÃ GAN TỤY TÔM DƯỚI ĐIỀU KIỆN NHIỄM THỰC NGHIỆM EHP
PHÂN TÍCH HỆ PHIÊN MÃ GAN TỤY TÔM DƯỚI ĐIỀU KIỆN NHIỄM THỰC NGHIỆM EHP KIỂM SOÁT STRESS CHO TÔM BẰNG LALPACK IMMUNE: CHIA SẺ TỪ MỘT NGƯỜI NUÔI TÔM THÀNH CÔNG
KIỂM SOÁT STRESS CHO TÔM BẰNG LALPACK IMMUNE: CHIA SẺ TỪ MỘT NGƯỜI NUÔI TÔM THÀNH CÔNG ĐỐM ĐEN (MELANIN) TRONG GAN TÔM – TỐT HAY XẤU?
ĐỐM ĐEN (MELANIN) TRONG GAN TÔM – TỐT HAY XẤU? BẢO VỆ GAN TỤY – CHÌA KHÓA NÂNG CAO TỶ LỆ THÀNH CÔNG TRONG NUÔI TÔM
BẢO VỆ GAN TỤY – CHÌA KHÓA NÂNG CAO TỶ LỆ THÀNH CÔNG TRONG NUÔI TÔM BẢO VỆ NGÀNH NUÔI TÔM BẰNG CÁC GIẢI PHÁP AN TOÀN SINH HỌC THÔNG MINH HƠN
BẢO VỆ NGÀNH NUÔI TÔM BẰNG CÁC GIẢI PHÁP AN TOÀN SINH HỌC THÔNG MINH HƠN PHÁC ĐỒ ĐIỀU TRỊ BỆNH TPD VÀ PHỤC HỒI TÔM
PHÁC ĐỒ ĐIỀU TRỊ BỆNH TPD VÀ PHỤC HỒI TÔM VI SINH KHÁNG VIBRIO ĐỘC LỰC CAO
VI SINH KHÁNG VIBRIO ĐỘC LỰC CAO VI SINH THÔNG MINH CHO NUÔI TÔM – TĂNG TRƯỞNG, CHẤT LƯỢNG NƯỚC VÀ SỨC KHỎE TỐT HƠN
VI SINH THÔNG MINH CHO NUÔI TÔM – TĂNG TRƯỞNG, CHẤT LƯỢNG NƯỚC VÀ SỨC KHỎE TỐT HƠN ĐỒNG HỮU CƠ THÚC ĐẨY TÍCH LŨY VÀ VẬN CHUYỂN ĐỒNG, TĂNG CƯỜNG KHẢ NĂNG CHỊU LẠNH VÀ SỨC KHỎE SINH LÝ CỦA TÔM THẺ CHÂN TRẮNG
ĐỒNG HỮU CƠ THÚC ĐẨY TÍCH LŨY VÀ VẬN CHUYỂN ĐỒNG, TĂNG CƯỜNG KHẢ NĂNG CHỊU LẠNH VÀ SỨC KHỎE SINH LÝ CỦA TÔM THẺ CHÂN TRẮNG TỔNG HỢP NGUYÊN NHÂN VÀ CƠ CHẾ TRẮNG ĐỤC CƠ Ở TÔM THẺ CHÂN TRẮNG TRONG AO NUÔI KHI THỜI TIẾT BIẾN ĐỘNG
TỔNG HỢP NGUYÊN NHÂN VÀ CƠ CHẾ TRẮNG ĐỤC CƠ Ở TÔM THẺ CHÂN TRẮNG TRONG AO NUÔI KHI THỜI TIẾT BIẾN ĐỘNG BỆNH TPD - "HIGHLY LETHAL VIBRIO DISEASE" - MỐI ĐE DỌA TOÀN CẦU TRONG NGÀNH NUÔI TÔM (Phần 2)
BỆNH TPD - "HIGHLY LETHAL VIBRIO DISEASE" - MỐI ĐE DỌA TOÀN CẦU TRONG NGÀNH NUÔI TÔM (Phần 2) BỆNH TPD - "HIGHLY LETHAL VIBRIO DISEASE" - MỐI ĐE DỌA TOÀN CẦU TRONG NGÀNH NUÔI TÔM (Phần 1)
BỆNH TPD - "HIGHLY LETHAL VIBRIO DISEASE" - MỐI ĐE DỌA TOÀN CẦU TRONG NGÀNH NUÔI TÔM (Phần 1) BỆNH FRANCISELLOSIS TRÊN CÁ RÔ PHI – THÁCH THỨC MỚI CHO NGƯỜI NUÔI
BỆNH FRANCISELLOSIS TRÊN CÁ RÔ PHI – THÁCH THỨC MỚI CHO NGƯỜI NUÔI QUY TRÌNH XỬ LÝ PHÂN TRẮNG (EHP VÀ TẢO)
QUY TRÌNH XỬ LÝ PHÂN TRẮNG (EHP VÀ TẢO) KẾT HỢP CLEVER VÀ TETRA MAX ĐỂ TĂNG HIỆU QUẢ ĐIỀU TRỊ BỆNH ĐƯỜNG RUỘT
KẾT HỢP CLEVER VÀ TETRA MAX ĐỂ TĂNG HIỆU QUẢ ĐIỀU TRỊ BỆNH ĐƯỜNG RUỘT HIỂU VỀ QUẢN LÝ VI SINH TRONG NUÔI TÔM ĐỂ CẢI THIỆN LỢI NHUẬN
HIỂU VỀ QUẢN LÝ VI SINH TRONG NUÔI TÔM ĐỂ CẢI THIỆN LỢI NHUẬN DẤU HIỆU NHẬN BIẾT SỚM SỰ SUY GIẢM CHỨC NĂNG GAN TUỴ Ở TÔM
DẤU HIỆU NHẬN BIẾT SỚM SỰ SUY GIẢM CHỨC NĂNG GAN TUỴ Ở TÔM NGỪA VÀ ĐIỀU TRỊ ĐỐM ĐEN TRÊN TÔM
NGỪA VÀ ĐIỀU TRỊ ĐỐM ĐEN TRÊN TÔM CHUYỂN CÁ AN TOÀN VÀ ĐẨY NHANH QUÁ TRÌNH LÀNH VẾT THƯƠNG VỚI DẪN XUẤT NẤM MEN ĐẶC HIỆU
CHUYỂN CÁ AN TOÀN VÀ ĐẨY NHANH QUÁ TRÌNH LÀNH VẾT THƯƠNG VỚI DẪN XUẤT NẤM MEN ĐẶC HIỆU QUẢN LÝ HỆ VI SINH VẬT TRONG NUÔI TÔM - HIỂU ĐÚNG ĐỂ NUÔI KHỎE, TRÚNG LỚN
QUẢN LÝ HỆ VI SINH VẬT TRONG NUÔI TÔM - HIỂU ĐÚNG ĐỂ NUÔI KHỎE, TRÚNG LỚN TÔM BỊ PHÂN TRẮNG – NÊN LÀM GÌ ĐỂ XỬ LÝ KỊP THỜI VÀ HIỆU QUẢ?
TÔM BỊ PHÂN TRẮNG – NÊN LÀM GÌ ĐỂ XỬ LÝ KỊP THỜI VÀ HIỆU QUẢ? ĐÁNH GIÁ KHẢ NĂNG KHÁNG KHUẨN CỦA CLEVER VÀ PROSUR ĐỐI VỚI CHỦNG VI KHUẨN VIBRIO PARAHAEMOLYTICUS VP4-24 GÂY BỆNH TPD TRÊN TÔM
ĐÁNH GIÁ KHẢ NĂNG KHÁNG KHUẨN CỦA CLEVER VÀ PROSUR ĐỐI VỚI CHỦNG VI KHUẨN VIBRIO PARAHAEMOLYTICUS VP4-24 GÂY BỆNH TPD TRÊN TÔM Sự tái phát thường xuyên của EMS/AHPNS/TPD có phải là kết quả của sự mất cân bằng sinh thái gây ra bởi việc sử dụng Chlorine?
Sự tái phát thường xuyên của EMS/AHPNS/TPD có phải là kết quả của sự mất cân bằng sinh thái gây ra bởi việc sử dụng Chlorine? TÁC DỤNG CỦA PHMB CHỐNG LẠI VIBRIO PARAHAEMOLYTICUS GÂY TPD TRÊN TÔM
TÁC DỤNG CỦA PHMB CHỐNG LẠI VIBRIO PARAHAEMOLYTICUS GÂY TPD TRÊN TÔM BỆNH NẤM TRẮNG Ở CÁ BIỂN, CÁC PHƯƠNG PHÁP PHÒNG VÀ TRỊ BỆNH
BỆNH NẤM TRẮNG Ở CÁ BIỂN, CÁC PHƯƠNG PHÁP PHÒNG VÀ TRỊ BỆNH KỸ THUẬT CHỌN GIỐNG THẢ, THỨC ĂN CHO CÁ BÓP
KỸ THUẬT CHỌN GIỐNG THẢ, THỨC ĂN CHO CÁ BÓP SALMON EVOLUTION DẪN ĐẦU TRONG SẢN XUẤT CÁ HỒI TRÊN CẠN
SALMON EVOLUTION DẪN ĐẦU TRONG SẢN XUẤT CÁ HỒI TRÊN CẠN CHẤT LƯỢNG NƯỚC AO NUÔI LÀ QUAN TRỌNG NHẤT CHO VỤ MÙA THÀNH CÔNG BÊN CẠNH CON GIỐNG SẠCH MẦM BỆNH
CHẤT LƯỢNG NƯỚC AO NUÔI LÀ QUAN TRỌNG NHẤT CHO VỤ MÙA THÀNH CÔNG BÊN CẠNH CON GIỐNG SẠCH MẦM BỆNH CHI PHÍ NUÔI TÔM SO VỚI GIÁ BÁN, YẾU TỐ NÀO QUAN TRỌNG HƠN?
CHI PHÍ NUÔI TÔM SO VỚI GIÁ BÁN, YẾU TỐ NÀO QUAN TRỌNG HƠN? CÂN BẰNG MÔI TRƯỜNG NUÔI BẰNG VI SINH ĐẶC HIỆU MAX 4000 NEW
CÂN BẰNG MÔI TRƯỜNG NUÔI BẰNG VI SINH ĐẶC HIỆU MAX 4000 NEW ĐỘ MẶN ẢNH HƯỞNG ĐẾN TỶ LỆ NHIỄM EHP Ở TÔM THẺ CHÂN TRẮNG NHƯ THẾ NÀO?
ĐỘ MẶN ẢNH HƯỞNG ĐẾN TỶ LỆ NHIỄM EHP Ở TÔM THẺ CHÂN TRẮNG NHƯ THẾ NÀO? ROBINS MCINTOSH CHIA SẺ NHỮNG ĐIỀU CẦN BIẾT VỀ EHP VÀ NUÔI TÔM
ROBINS MCINTOSH CHIA SẺ NHỮNG ĐIỀU CẦN BIẾT VỀ EHP VÀ NUÔI TÔM CÁCH TIẾP CẬN MỚI BẰNG SINH HỌC ĐỂ GIẢM BÙNG PHÁT EHP
CÁCH TIẾP CẬN MỚI BẰNG SINH HỌC ĐỂ GIẢM BÙNG PHÁT EHP CÂY TẦM MA TRONG THỨC ĂN THỦY SẢN: NHÀ MÁY NĂNG LƯỢNG XANH TRÊN CẠN GIÚP CẢI THIỆN SỨC KHỎE CÁ
CÂY TẦM MA TRONG THỨC ĂN THỦY SẢN: NHÀ MÁY NĂNG LƯỢNG XANH TRÊN CẠN GIÚP CẢI THIỆN SỨC KHỎE CÁ BACTERIOPHAGE - GIẢI PHÁP THAY THẾ ĐỂ KIỂM SOÁT VIBRIO PARAHAEMOLYTICUS TRONG NUÔI TÔM
BACTERIOPHAGE - GIẢI PHÁP THAY THẾ ĐỂ KIỂM SOÁT VIBRIO PARAHAEMOLYTICUS TRONG NUÔI TÔM ẤN ĐỘ : NUÔI GHÉP TÔM CÀNG XANH CẢI TIẾN VÀ CÁ MANG LẠI HIỆU QUẢ CAO
ẤN ĐỘ : NUÔI GHÉP TÔM CÀNG XANH CẢI TIẾN VÀ CÁ MANG LẠI HIỆU QUẢ CAO GIẢI PHÁP THAY THẾ BỀN VỮNG TRONG NUÔI VÀ CHẾ BIẾN RONG BIỂN TẠI AO CỦA INDONESIA
GIẢI PHÁP THAY THẾ BỀN VỮNG TRONG NUÔI VÀ CHẾ BIẾN RONG BIỂN TẠI AO CỦA INDONESIA ĐẾN LÚC THAY THẾ CÁC BỘ LỌC SINH HỌC TRUYỀN THỐNG TRONG RAS CHƯA?
ĐẾN LÚC THAY THẾ CÁC BỘ LỌC SINH HỌC TRUYỀN THỐNG TRONG RAS CHƯA? PROBIOTICS TRONG THỨC ĂN VÀ QUẢN LÝ NƯỚC BẰNG VI SINH GIÚP CẢI THIỆN HIỆU SUẤT VÀ SỨC KHỎE TÔM NUÔI MỘT CÁCH ĐÁNG KỂ
PROBIOTICS TRONG THỨC ĂN VÀ QUẢN LÝ NƯỚC BẰNG VI SINH GIÚP CẢI THIỆN HIỆU SUẤT VÀ SỨC KHỎE TÔM NUÔI MỘT CÁCH ĐÁNG KỂ TĂNG CƯỜNG KHẢ NĂNG MIỄN DỊCH VÀ BẢO VỆ DA CÁ
TĂNG CƯỜNG KHẢ NĂNG MIỄN DỊCH VÀ BẢO VỆ DA CÁ TẦM QUAN TRỌNG CỦA VIỆC ỔN ĐỊNH MÔI TRƯỜNG NƯỚC
TẦM QUAN TRỌNG CỦA VIỆC ỔN ĐỊNH MÔI TRƯỜNG NƯỚC NHỮNG PHÁT HIỆN GẦN ĐÂY VỀ NHIỄM EHP Ở TÔM
NHỮNG PHÁT HIỆN GẦN ĐÂY VỀ NHIỄM EHP Ở TÔM TÔM LỘT DÍNH VỎ VÀ CÁCH XỬ LÝ
TÔM LỘT DÍNH VỎ VÀ CÁCH XỬ LÝ KIỂM SOÁT HÀU CHỈ TRONG AO TÔM
KIỂM SOÁT HÀU CHỈ TRONG AO TÔM MỦ ĐUÔI VÀ CÁCH XỬ LÝ
MỦ ĐUÔI VÀ CÁCH XỬ LÝ KIỂM SOÁT TẢO ĐỘC TRONG AO
KIỂM SOÁT TẢO ĐỘC TRONG AO HIỂU BIẾT MỚI VỀ AEROMONAS HYDROPHILA TRONG NUÔI TRỒNG THỦY SẢN
HIỂU BIẾT MỚI VỀ AEROMONAS HYDROPHILA TRONG NUÔI TRỒNG THỦY SẢN GIẢI PHÁP THAY THẾ NÀO ĐỐI VỚI VIỆC CẮT BỎ CUỐNG MẮT TÔM
GIẢI PHÁP THAY THẾ NÀO ĐỐI VỚI VIỆC CẮT BỎ CUỐNG MẮT TÔM PHÒNG BỆNH THỐI ĐUÔI TRÊN CÁ TRA GIỐNG
PHÒNG BỆNH THỐI ĐUÔI TRÊN CÁ TRA GIỐNG HƯỚNG ĐẾN GIẢI PHÁP NUÔI TÔM BỀN VỮNG CHO TƯƠNG LAI
HƯỚNG ĐẾN GIẢI PHÁP NUÔI TÔM BỀN VỮNG CHO TƯƠNG LAI DẪN XUẤT NẤM MEN THẾ HỆ MỚI: TĂNG CƯỜNG MIỄN DỊCH, NÂNG CAO HIỆU SUẤT NUÔI TÔM
DẪN XUẤT NẤM MEN THẾ HỆ MỚI: TĂNG CƯỜNG MIỄN DỊCH, NÂNG CAO HIỆU SUẤT NUÔI TÔM KHÁM PHÁ CHIẾN LƯỢC VÀ GIẢI PHÁP ĐỂ ĐỐI PHÓ VỚI DỊCH BỆNH TRONG NUÔI TÔM ẤN ĐỘ
KHÁM PHÁ CHIẾN LƯỢC VÀ GIẢI PHÁP ĐỂ ĐỐI PHÓ VỚI DỊCH BỆNH TRONG NUÔI TÔM ẤN ĐỘ ỨNG DỤNG CÔNG NGHỆ DI TRUYỀN TRONG CHỌN GIỐNG CÁ CHÉP
ỨNG DỤNG CÔNG NGHỆ DI TRUYỀN TRONG CHỌN GIỐNG CÁ CHÉP QUY TRÌNH ƯƠNG CÁ TRA BỘT 15 NGÀY ĐẦU CHO TỶ LỆ ĐẬU CAO
QUY TRÌNH ƯƠNG CÁ TRA BỘT 15 NGÀY ĐẦU CHO TỶ LỆ ĐẬU CAO CÁCH NHẬN BIẾT VÀ NGĂN CHẶN SỰ BÙNG PHÁT CỦA STREPTOCOCCUS TRONG NUÔI CÁ
CÁCH NHẬN BIẾT VÀ NGĂN CHẶN SỰ BÙNG PHÁT CỦA STREPTOCOCCUS TRONG NUÔI CÁ ỨNG DỤNG VI SINH ĐỂ GIẢM ĐỘC LỰC VIBRIO VÀ BỆNH HẬU ẤU TRÙNG THỦY TINH TRÊN TÔM
ỨNG DỤNG VI SINH ĐỂ GIẢM ĐỘC LỰC VIBRIO VÀ BỆNH HẬU ẤU TRÙNG THỦY TINH TRÊN TÔM MỨC TIÊU THỤ OXY CỦA TÔM THẺ CHÂN TRẮNG TRONG AO THÂM CANH DỰA TRÊN HỆ THỐNG MÔ HÌNH ĐỘNG
MỨC TIÊU THỤ OXY CỦA TÔM THẺ CHÂN TRẮNG TRONG AO THÂM CANH DỰA TRÊN HỆ THỐNG MÔ HÌNH ĐỘNG NHỮNG NGUY CƠ CỦA VIỆC THÂM CANH QUÁ MỨC TRONG NUÔI TÔM
NHỮNG NGUY CƠ CỦA VIỆC THÂM CANH QUÁ MỨC TRONG NUÔI TÔM 2 GIỐNG MỚI TÔM THẺ CHÂN TRẮNG ĐỀ KHÁNG DỊCH BỆNH
2 GIỐNG MỚI TÔM THẺ CHÂN TRẮNG ĐỀ KHÁNG DỊCH BỆNH LỖ HỔNG NGUY HIỂM TRONG XÉT NGHIỆM VIRUS HỘI CHỨNG ĐỐM TRẮNG
LỖ HỔNG NGUY HIỂM TRONG XÉT NGHIỆM VIRUS HỘI CHỨNG ĐỐM TRẮNG HIỂU VỀ NITRIT VÀ HẠN CHẾ SỰ HIỆN DIỆN CỦA NÓ TRONG RAS VÀ AO NUÔI THỦY SẢN
HIỂU VỀ NITRIT VÀ HẠN CHẾ SỰ HIỆN DIỆN CỦA NÓ TRONG RAS VÀ AO NUÔI THỦY SẢN GIẢM THIỂU DỊCH BỆNH, TĂNG NĂNG SUẤT AO NUÔI
GIẢM THIỂU DỊCH BỆNH, TĂNG NĂNG SUẤT AO NUÔI ĐIỀU CHỈNH HỆ VI SINH VẬT TRONG VÀ NGOÀI CƠ THỂ TÔM
ĐIỀU CHỈNH HỆ VI SINH VẬT TRONG VÀ NGOÀI CƠ THỂ TÔM QUY TRÌNH CHĂM SÓC TÔM THẺ CHÂN TRẮNG BỐ MẸ VÀ SẢN XUẤT NAUPLIUS SẠCH BỆNH
QUY TRÌNH CHĂM SÓC TÔM THẺ CHÂN TRẮNG BỐ MẸ VÀ SẢN XUẤT NAUPLIUS SẠCH BỆNH VACCINE PHÒNG BỆNH TRONG THỦY SẢN
VACCINE PHÒNG BỆNH TRONG THỦY SẢN TRANG TRẠI NUÔI CÁ RAS BIẾN BÙN THẢI THÀNH PHÂN BÓN
TRANG TRẠI NUÔI CÁ RAS BIẾN BÙN THẢI THÀNH PHÂN BÓN LÀM THẾ NÀO ĐỂ ĐẢM BẢO SỨC KHỎE TÔM NGĂN NGỪA BỆNH EHP? 8 BIỆN PHÁP HIỆU QUẢ BẠN NÊN BIẾT
LÀM THẾ NÀO ĐỂ ĐẢM BẢO SỨC KHỎE TÔM NGĂN NGỪA BỆNH EHP? 8 BIỆN PHÁP HIỆU QUẢ BẠN NÊN BIẾT VÙNG NƯỚC ẤM LÀM GIẢM NGUY CƠ BỆNH ĐỐM TRẮNG
VÙNG NƯỚC ẤM LÀM GIẢM NGUY CƠ BỆNH ĐỐM TRẮNG ẢNH HƯỞNG NỒNG ĐỘ MAGIE ĐẾN TĂNG TRƯỞNG CỦA TÔM
ẢNH HƯỞNG NỒNG ĐỘ MAGIE ĐẾN TĂNG TRƯỞNG CỦA TÔM BỆNH HẬU ẤU TRÙNG THỦY TINH TRÊN TÔM THẺ CHÂN TRẮNG
BỆNH HẬU ẤU TRÙNG THỦY TINH TRÊN TÔM THẺ CHÂN TRẮNG BỔ SUNG PIPERINE GIÚP TĂNG NĂNG SUẤT VÀ SỨC KHỎE ẤU TRÙNG TÔM THẺ CHÂN TRẮNG
BỔ SUNG PIPERINE GIÚP TĂNG NĂNG SUẤT VÀ SỨC KHỎE ẤU TRÙNG TÔM THẺ CHÂN TRẮNG CHẤT KHỬ TRÙNG NƯỚC TƯƠNG THÍCH VỚI RAS?
CHẤT KHỬ TRÙNG NƯỚC TƯƠNG THÍCH VỚI RAS? PaRAS MÔ HÌNH KẾ NHIỆM RAS HOÀN HẢO
PaRAS MÔ HÌNH KẾ NHIỆM RAS HOÀN HẢO ĐỘC TÍNH CỦA HYDRO SUNFUA: TÌM HIỂU VÀ GIẢM THIỂU TRONG CÁC HỆ THỐNG NUÔI TRỒNG THỦY SẢN TUẦN HOÀN
ĐỘC TÍNH CỦA HYDRO SUNFUA: TÌM HIỂU VÀ GIẢM THIỂU TRONG CÁC HỆ THỐNG NUÔI TRỒNG THỦY SẢN TUẦN HOÀN MỘT TẦM NHÌN MỚI CHO MÁY BƠM CÁNH QUẠT
MỘT TẦM NHÌN MỚI CHO MÁY BƠM CÁNH QUẠT MỘT SỐ BỆNH PHỔ BIẾN TRÊN TÔM
MỘT SỐ BỆNH PHỔ BIẾN TRÊN TÔM BỆNH ĐỐM ĐỎ TRÊN CÁ KOI
BỆNH ĐỐM ĐỎ TRÊN CÁ KOI 4 CÁCH TỐI ƯU HÓA TÍNH ỔN ĐỊNH CỦA HỆ THỐNG BIOFLOC
4 CÁCH TỐI ƯU HÓA TÍNH ỔN ĐỊNH CỦA HỆ THỐNG BIOFLOC ĐỐI MẶT VỚI GIÁ TÔM THẤP: NGƯỜI NUÔI CẦN LÀM GÌ?
ĐỐI MẶT VỚI GIÁ TÔM THẤP: NGƯỜI NUÔI CẦN LÀM GÌ? ĐẠM THỨC ĂN VÀ TĂNG TRƯỞNG CỦA TÔM
ĐẠM THỨC ĂN VÀ TĂNG TRƯỞNG CỦA TÔM SẮC TỐ CƠ THỂ VÀ TÌNH TRẠNG SỨC KHỎE CỦA TÔM
SẮC TỐ CƠ THỂ VÀ TÌNH TRẠNG SỨC KHỎE CỦA TÔM VI TẢO GIÚP TÔM KHÁNG VIRUS ĐẦU VÀNG YHV
VI TẢO GIÚP TÔM KHÁNG VIRUS ĐẦU VÀNG YHV TIẾT LỘ CƠ CHẾ ĐẰNG SAU KHẢ NĂNG CHỊU NHIỆT Ở TÔM HE
TIẾT LỘ CƠ CHẾ ĐẰNG SAU KHẢ NĂNG CHỊU NHIỆT Ở TÔM HE CÁC NHÀ NGHIÊN CỨU TRUNG QUỐC SỬ DỤNG CHỈNH SỬA GEN ĐỂ LOẠI BỎ XƯƠNG NHỎ TỪ CÁ DIẾC
CÁC NHÀ NGHIÊN CỨU TRUNG QUỐC SỬ DỤNG CHỈNH SỬA GEN ĐỂ LOẠI BỎ XƯƠNG NHỎ TỪ CÁ DIẾC NẤM MEN BIẾN ĐỔI GEN CHỨNG MINH NGUỒN ASTAXANTHIN ĐẦY HỨA HẸN CHO THỨC ĂN TÔM
NẤM MEN BIẾN ĐỔI GEN CHỨNG MINH NGUỒN ASTAXANTHIN ĐẦY HỨA HẸN CHO THỨC ĂN TÔM CHẾ ĐỘ ĂN GIÚP TÔM TĂNG KHẢ NĂNG MIỄN DỊCH VỚI NẤM FUSARIUM
CHẾ ĐỘ ĂN GIÚP TÔM TĂNG KHẢ NĂNG MIỄN DỊCH VỚI NẤM FUSARIUM QUẢN LÝ VÀ KIỂM SOÁT NẤM ĐỒNG TIỀN TRONG AO LÀ MỘT TRONG NHỮNG BÍ QUYẾT QUẢN LÝ BỆNH ĐƯỜNG RUỘT TRÊN TÔM
QUẢN LÝ VÀ KIỂM SOÁT NẤM ĐỒNG TIỀN TRONG AO LÀ MỘT TRONG NHỮNG BÍ QUYẾT QUẢN LÝ BỆNH ĐƯỜNG RUỘT TRÊN TÔM PHƯƠNG PHÁP PHÁT HIỆN EHP BẰNG KÍNH HIỂN VI
PHƯƠNG PHÁP PHÁT HIỆN EHP BẰNG KÍNH HIỂN VI TẦM QUAN TRỌNG CỦA KHOÁNG TRONG NUÔI CÁ
TẦM QUAN TRỌNG CỦA KHOÁNG TRONG NUÔI CÁ TÁC ĐỘNG CỦA HYDRO SUNPHIDE TRONG HỆ THỐNG NUÔI TUẦN HOÀN (RAS)
TÁC ĐỘNG CỦA HYDRO SUNPHIDE TRONG HỆ THỐNG NUÔI TUẦN HOÀN (RAS) GIAI ĐOẠN XỔ NỘI - NGOẠI KÝ SINH AN TOÀN TRONG NUÔI CÁ TRA
GIAI ĐOẠN XỔ NỘI - NGOẠI KÝ SINH AN TOÀN TRONG NUÔI CÁ TRA NUÔI TÔM SÚ SẼ GIA TĂNG ?
NUÔI TÔM SÚ SẼ GIA TĂNG ? NGUỒN CARBONHYDRATE CHO BIOFLOC NÀO TỐT HƠN – BỘT MÌ HAY MẬT ĐƯỜNG?
NGUỒN CARBONHYDRATE CHO BIOFLOC NÀO TỐT HƠN – BỘT MÌ HAY MẬT ĐƯỜNG? BẢO VỆ TÔM BẰNG RNA NANOVACCINE MỚI CHỐNG LẠI VIRUS GÂY HỘI CHỨNG ĐỐM TRẮNG
BẢO VỆ TÔM BẰNG RNA NANOVACCINE MỚI CHỐNG LẠI VIRUS GÂY HỘI CHỨNG ĐỐM TRẮNG GIẢI PHÁP CHO KHỦNG HOẢNG NUÔI TRỒNG TẠI CHÂU Á TỪ NHÀ SẢN XUẤT TÔM HOA KỲ
GIẢI PHÁP CHO KHỦNG HOẢNG NUÔI TRỒNG TẠI CHÂU Á TỪ NHÀ SẢN XUẤT TÔM HOA KỲ VỰC DẬY NGÀNH TÔM SÚ
VỰC DẬY NGÀNH TÔM SÚ BỔ SUNG NUCLEOTIDE MANG LẠI LỢI ÍCH GÌ CHO TÔM?
BỔ SUNG NUCLEOTIDE MANG LẠI LỢI ÍCH GÌ CHO TÔM? CÁCH SỬ DỤNG THỨC ĂN TRONG NUÔI TRỒNG THỦY SẢN HIỆU QUẢ
CÁCH SỬ DỤNG THỨC ĂN TRONG NUÔI TRỒNG THỦY SẢN HIỆU QUẢ OCEAN ARKS TECH – TRANG TRẠI DI ĐỘNG MỞ RA TƯƠNG LAI MỚI CHO NGHỀ NUÔI BIỂN
OCEAN ARKS TECH – TRANG TRẠI DI ĐỘNG MỞ RA TƯƠNG LAI MỚI CHO NGHỀ NUÔI BIỂN SỬ DỤNG CHẤT CHỐNG MỐC TRONG THỨC ĂN THỦY SẢN
SỬ DỤNG CHẤT CHỐNG MỐC TRONG THỨC ĂN THỦY SẢN CHĂM SÓC VÀ PHÒNG BỆNH CHO CÁ TRONG GIAI ĐOẠN GIAO MÙA
CHĂM SÓC VÀ PHÒNG BỆNH CHO CÁ TRONG GIAI ĐOẠN GIAO MÙA SỬ DỤNG CHẤT NHŨ HÓA TRONG THỨC ĂN THỦY SẢN
SỬ DỤNG CHẤT NHŨ HÓA TRONG THỨC ĂN THỦY SẢN HỆ VI SINH VẬT TRONG AO NUÔI DƯỚI TÁC ĐỘNG CỦA AXIT SILICIC
HỆ VI SINH VẬT TRONG AO NUÔI DƯỚI TÁC ĐỘNG CỦA AXIT SILICIC STRESS TRÊN CÁ – NGUYÊN NHÂN, DẤU HIỆU VÀ CÁCH KHẮC PHỤC
STRESS TRÊN CÁ – NGUYÊN NHÂN, DẤU HIỆU VÀ CÁCH KHẮC PHỤC TƯƠNG LAI CỦA XÉT NGHIỆM BỆNH TRÊN TÔM DƯỚI GÓC NHÌN CHUYÊN GIA GENICS
TƯƠNG LAI CỦA XÉT NGHIỆM BỆNH TRÊN TÔM DƯỚI GÓC NHÌN CHUYÊN GIA GENICS SO SÁNH VIỆC SỬ DỤNG TÀI NGUYÊN TRONG NUÔI TÔM, PHẦN 3: NĂNG LƯỢNG
SO SÁNH VIỆC SỬ DỤNG TÀI NGUYÊN TRONG NUÔI TÔM, PHẦN 3: NĂNG LƯỢNG TÁC ĐỘNG CỦA ĐÈN LED MÀU ĐẾN SỰ TĂNG TRƯỞNG CỦA TÔM VÀ CHẤT LƯỢNG NƯỚC TRONG MÔ HÌNH BIOFLOC
TÁC ĐỘNG CỦA ĐÈN LED MÀU ĐẾN SỰ TĂNG TRƯỞNG CỦA TÔM VÀ CHẤT LƯỢNG NƯỚC TRONG MÔ HÌNH BIOFLOC Nồng độ Nitrat cao có thể gây độc cho tôm.
Nồng độ Nitrat cao có thể gây độc cho tôm. So sánh việc sử dụng tài nguyên trong nuôi tôm - phần 1: Đất
So sánh việc sử dụng tài nguyên trong nuôi tôm - phần 1: Đất CÁC PHƯƠNG PHÁP XỬ LÝ GIẢM STRESS CHO TÔM KHI VẬN CHUYỂN
CÁC PHƯƠNG PHÁP XỬ LÝ GIẢM STRESS CHO TÔM KHI VẬN CHUYỂN KINH NGHIỆM KIỂM SOÁT TẢO TRONG AO
KINH NGHIỆM KIỂM SOÁT TẢO TRONG AO Nghiên cứu cách tôm phản ứng với stress nhiệt độ cao
Nghiên cứu cách tôm phản ứng với stress nhiệt độ cao BỆNH SƯNG BÓNG HƠI TRÊN CÁ TRA CÓ THỂ DO NHIỀU HƠN MỘT TÁC NHÂN GÂY RA
BỆNH SƯNG BÓNG HƠI TRÊN CÁ TRA CÓ THỂ DO NHIỀU HƠN MỘT TÁC NHÂN GÂY RA Giải pháp sinh học kiểm soát tảo trong ao nuôi cá tra
Giải pháp sinh học kiểm soát tảo trong ao nuôi cá tra Tác động của Agavin với hệ vi sinh vật đường ruột tôm thẻ chân trắng
Tác động của Agavin với hệ vi sinh vật đường ruột tôm thẻ chân trắng Xử lý nước thải nuôi thủy sản biển bằng cây Salicornia
Xử lý nước thải nuôi thủy sản biển bằng cây Salicornia DINH DƯỠNG GIAI ĐOẠN ĐẦU ẢNH HƯỞNG TRONG SUỐT QUÁ TRÌNH SINH TRƯỞNG VÀ PHÁT TRIỂN CỦA CÁ TRONG CẢ VỤ NUÔI.
DINH DƯỠNG GIAI ĐOẠN ĐẦU ẢNH HƯỞNG TRONG SUỐT QUÁ TRÌNH SINH TRƯỞNG VÀ PHÁT TRIỂN CỦA CÁ TRONG CẢ VỤ NUÔI. HỘI CHỨNG PHÂN TRẮNG Ở TÔM CÓ THỂ DO NHIỀU HƠN MỘT MẦM BỆNH GÂY RA
HỘI CHỨNG PHÂN TRẮNG Ở TÔM CÓ THỂ DO NHIỀU HƠN MỘT MẦM BỆNH GÂY RA Hội chứng phân trắng: Hiểu biết mới nhất và các biện pháp phòng ngừa
Hội chứng phân trắng: Hiểu biết mới nhất và các biện pháp phòng ngừa Dùng vi tảo nâng cao chất lượng nước và năng suất nuôi tôm thẻ.
Dùng vi tảo nâng cao chất lượng nước và năng suất nuôi tôm thẻ. Sử dụng Lutein để thay thế Astaxanthin trong khẩu phần ăn tôm thẻ chân trắng
Sử dụng Lutein để thay thế Astaxanthin trong khẩu phần ăn tôm thẻ chân trắng ĐỘ MẶN KHÁC NHAU CÓ THỂ LÀM THAY ĐỔI THÀNH PHẦN VI KHUẨN TRONG HỆ THỐNG RAS
ĐỘ MẶN KHÁC NHAU CÓ THỂ LÀM THAY ĐỔI THÀNH PHẦN VI KHUẨN TRONG HỆ THỐNG RAS MỐI LO NGẠI VỀ TÍNH AN TOÀN CỦA PROBIOTIC
MỐI LO NGẠI VỀ TÍNH AN TOÀN CỦA PROBIOTIC THỬ NGHIỆM ƯƠNG TÔM THẺ CHÂN TRẮNG TRONG NƯỚC BIỂN VÀ NƯỚC CÓ ĐỘ MẶN THẤP SỬ DỤNG HỆ THỐNG SYNBIOTIC
THỬ NGHIỆM ƯƠNG TÔM THẺ CHÂN TRẮNG TRONG NƯỚC BIỂN VÀ NƯỚC CÓ ĐỘ MẶN THẤP SỬ DỤNG HỆ THỐNG SYNBIOTIC HIỂU BIẾT THÊM THÔNG TIN VỀ VI SINH
HIỂU BIẾT THÊM THÔNG TIN VỀ VI SINH 10 giải pháp quản lý ao nuôi mùa lạnh
10 giải pháp quản lý ao nuôi mùa lạnh Lợi ích của việc bổ sung Bacillus Venezensis vào thức ăn của tôm thẻ chân trắng
Lợi ích của việc bổ sung Bacillus Venezensis vào thức ăn của tôm thẻ chân trắng Tăng trưởng bằng ánh sáng xanh – Triển vọng trong nuôi cá bơn
Tăng trưởng bằng ánh sáng xanh – Triển vọng trong nuôi cá bơn Nhận biết và phòng ngừa bệnh đốm trắng
Nhận biết và phòng ngừa bệnh đốm trắng Isoquinoline Alkaloids và hệ thống miễn dịch tôm thẻ chân trắng
Isoquinoline Alkaloids và hệ thống miễn dịch tôm thẻ chân trắng Ảnh hưởng của Lactobacillus đến sự sinh trưởng của tôm thẻ chân trắng trong thử thách cảm nhiễm Vibrio harveyi.
Ảnh hưởng của Lactobacillus đến sự sinh trưởng của tôm thẻ chân trắng trong thử thách cảm nhiễm Vibrio harveyi. Xác định tác nhân lây nhiễm bệnh Translucent Postlarvae Disease - TPD ở tôm thẻ chân trắng
Xác định tác nhân lây nhiễm bệnh Translucent Postlarvae Disease - TPD ở tôm thẻ chân trắng PHÂN TÍCH TÍNH KINH TẾ TRONG MÔ HÌNH NUÔI TÔM SIÊU THÂM CANH KHÉP KÍN Ở NHẬT BẢN
PHÂN TÍCH TÍNH KINH TẾ TRONG MÔ HÌNH NUÔI TÔM SIÊU THÂM CANH KHÉP KÍN Ở NHẬT BẢN MÔI TRƯỜNG, CỘNG ĐỒNG VI KHUẨN VÀ SỰ BÙNG PHÁT BỆNH PHÂN TRẮNG (WFD) TRONG AO NUÔI TÔM
MÔI TRƯỜNG, CỘNG ĐỒNG VI KHUẨN VÀ SỰ BÙNG PHÁT BỆNH PHÂN TRẮNG (WFD) TRONG AO NUÔI TÔM PHẢN ỨNG CỦA TÔM THẺ CHÂN TRẮNG VỚI BIẾN ĐỘNG NHIỆT ĐỘ Ở ĐỘ MẶN THẤP
PHẢN ỨNG CỦA TÔM THẺ CHÂN TRẮNG VỚI BIẾN ĐỘNG NHIỆT ĐỘ Ở ĐỘ MẶN THẤP LÀM THẾ NÀO ĐỂ SỬ DỤNG VI SINH MỘT CÁCH CÓ HIỆU QUẢ?
LÀM THẾ NÀO ĐỂ SỬ DỤNG VI SINH MỘT CÁCH CÓ HIỆU QUẢ? SELENIUM - KHOÁNG CHẤT ĐA CÔNG DỤNG
SELENIUM - KHOÁNG CHẤT ĐA CÔNG DỤNG KÍCH THÍCH SINH SẢN NHÂN TẠO CÁ CHỐT BÔNG PSEUDOMYSTUS SIAMENSIS
KÍCH THÍCH SINH SẢN NHÂN TẠO CÁ CHỐT BÔNG PSEUDOMYSTUS SIAMENSIS NGHIÊN CỨU VỀ CẮT BỎ CUỐNG MẮT TÔM CỦA SIMAO ZACARIAS
NGHIÊN CỨU VỀ CẮT BỎ CUỐNG MẮT TÔM CỦA SIMAO ZACARIAS ẢNH HƯỞNG CỦA TẢO SPIRULINA PLATENSIS ĐẾN TĂNG TRƯỞNG CỦA TÔM THẺ
ẢNH HƯỞNG CỦA TẢO SPIRULINA PLATENSIS ĐẾN TĂNG TRƯỞNG CỦA TÔM THẺ DẦU NHUYỄN THỂ - PHỤ GIA QUYỀN NĂNG
DẦU NHUYỄN THỂ - PHỤ GIA QUYỀN NĂNG PHỤ GIA THỨC ĂN THỦY SẢN TỪ NGÀNH BIA
PHỤ GIA THỨC ĂN THỦY SẢN TỪ NGÀNH BIA THÀNH PHẦN CỦA HỆ VI KHUẨN TRÊN ẤU TRÙNG TÔM THẺ CHÂN TRẮNG
THÀNH PHẦN CỦA HỆ VI KHUẨN TRÊN ẤU TRÙNG TÔM THẺ CHÂN TRẮNG ĐÁNH GIÁ ẢNH HƯỞNG CỦA STRESS pH DÀI HẠN ĐẾN TÔM THẺ CHÂN TRẮNG
ĐÁNH GIÁ ẢNH HƯỞNG CỦA STRESS pH DÀI HẠN ĐẾN TÔM THẺ CHÂN TRẮNG Khai thác bột côn trùng cho thủy sản
Khai thác bột côn trùng cho thủy sản LÊN MEN THỨC ĂN CHO TÔM THẺ CHÂN TRẮNG
LÊN MEN THỨC ĂN CHO TÔM THẺ CHÂN TRẮNG TÔM NHIỄM GREGARINE MÙA NẮNG NÓNG
TÔM NHIỄM GREGARINE MÙA NẮNG NÓNG CHẤT KÍCH THÍCH MIỄN DỊCH
CHẤT KÍCH THÍCH MIỄN DỊCH TÁC DỤNG HIỆP ĐỒNG CỦA TẢO SPIRULINA PLATENSIS VÀ VI SINH BACILLUS AMYLOLIQUEFACIENS
TÁC DỤNG HIỆP ĐỒNG CỦA TẢO SPIRULINA PLATENSIS VÀ VI SINH BACILLUS AMYLOLIQUEFACIENS LÀM SAO TĂNG HIỆU QUẢ TRONG NUÔI TÔM
LÀM SAO TĂNG HIỆU QUẢ TRONG NUÔI TÔM NUÔI TÔM THẺ CHÂN TRẮNG MẬT ĐỘ CAO
NUÔI TÔM THẺ CHÂN TRẮNG MẬT ĐỘ CAO BACILLUS VELEZENSIS – CHỦNG VI SINH MỚI PHÂN LẬP TỪ LOÀI PHỔ BIẾN Ở VIỆT NAM
BACILLUS VELEZENSIS – CHỦNG VI SINH MỚI PHÂN LẬP TỪ LOÀI PHỔ BIẾN Ở VIỆT NAM NUCLEOTIDE GIÚP TÔM THẺ CHỐNG CHỌI STRESS AMONIAC
NUCLEOTIDE GIÚP TÔM THẺ CHỐNG CHỌI STRESS AMONIAC VIRUS GÂY BỆNH THÂN THỦY TINH Ở TÔM GIỐNG
VIRUS GÂY BỆNH THÂN THỦY TINH Ở TÔM GIỐNG ĐÁNH GIÁ TĂNG TRƯỞNG BÙ Ở TÔM THẺ CHÂN TRẮNG TRONG HỆ THỐNG BIOFLOC
ĐÁNH GIÁ TĂNG TRƯỞNG BÙ Ở TÔM THẺ CHÂN TRẮNG TRONG HỆ THỐNG BIOFLOC BÁO CÁO VÀ MÔ TẢ ĐẦU TIÊN VỀ BỆNH DIV1 TRÊN TÔM CÀNG
BÁO CÁO VÀ MÔ TẢ ĐẦU TIÊN VỀ BỆNH DIV1 TRÊN TÔM CÀNG Tối ưu hóa quản lý ao nuôi tôm bằng phương pháp xử lý nước
Tối ưu hóa quản lý ao nuôi tôm bằng phương pháp xử lý nước SỬ DỤNG CHIẾT XUẤT BETAGLUCAN TỪ RONG BIỂN ĐỂ TĂNG SỨC ĐỀ KHÁNG CỦA TÔM BIỂN
SỬ DỤNG CHIẾT XUẤT BETAGLUCAN TỪ RONG BIỂN ĐỂ TĂNG SỨC ĐỀ KHÁNG CỦA TÔM BIỂN ẢNH HƯỞNG CỦA ĐỘ KIỀM LÊN TĂNG TRƯỞNG, TỶ LỆ SỐNG CỦA ẤU TRÙNG VÀ HẬU ẤU TRÙNG TÔM BIỂN
ẢNH HƯỞNG CỦA ĐỘ KIỀM LÊN TĂNG TRƯỞNG, TỶ LỆ SỐNG CỦA ẤU TRÙNG VÀ HẬU ẤU TRÙNG TÔM BIỂN TẦM QUAN TRỌNG CỦA pH TRONG MÔI TRƯỜNG AO NUÔI TRỒNG THỦY SẢN
TẦM QUAN TRỌNG CỦA pH TRONG MÔI TRƯỜNG AO NUÔI TRỒNG THỦY SẢN CÔNG NGHỆ BLOCKCHAIN VÀ VI SINH TRONG NUÔI TRỒNG THỦY SẢN
CÔNG NGHỆ BLOCKCHAIN VÀ VI SINH TRONG NUÔI TRỒNG THỦY SẢN TĂNG CƯỜNG QUẢN LÝ CHẤT LƯỢNG TÔM GIỐNG VÀ NGUỒN GỐC TÔM BỐ MẸ.
TĂNG CƯỜNG QUẢN LÝ CHẤT LƯỢNG TÔM GIỐNG VÀ NGUỒN GỐC TÔM BỐ MẸ. HỘI CHỨNG PHÂN TRẮNG TRÊN TÔM – DẤU HIỆU BAN ĐẦU CỦA EHP?
HỘI CHỨNG PHÂN TRẮNG TRÊN TÔM – DẤU HIỆU BAN ĐẦU CỦA EHP? ẢNH HƯỞNG CỦA TUỔI VÀ KÍCH CỠ ĐẾN KHẢ NĂNG SINH SẢN CỦA TÔM THẺ CHÂN TRẮNG BỐ MẸ
ẢNH HƯỞNG CỦA TUỔI VÀ KÍCH CỠ ĐẾN KHẢ NĂNG SINH SẢN CỦA TÔM THẺ CHÂN TRẮNG BỐ MẸ NGƯỜI NUÔI TÔM CÓ THỂ TẠO RA LỢI NHUẬN NẾU CÓ SỰ ĐẦU TƯ VỀ CON GIỐNG, NGUỒN THỨC ĂN VÀ CHẾ ĐỘ QUẢN LÝ
NGƯỜI NUÔI TÔM CÓ THỂ TẠO RA LỢI NHUẬN NẾU CÓ SỰ ĐẦU TƯ VỀ CON GIỐNG, NGUỒN THỨC ĂN VÀ CHẾ ĐỘ QUẢN LÝ SỬ DỤNG HỖN HỢP PROBIOTIC SẼ HIỆU QUẢ HƠN ĐƠN LẺ
SỬ DỤNG HỖN HỢP PROBIOTIC SẼ HIỆU QUẢ HƠN ĐƠN LẺ Bổ sung nerolidol giúp cá rô phi tăng trưởng và tăng chất lượng thịt
Bổ sung nerolidol giúp cá rô phi tăng trưởng và tăng chất lượng thịt Vi tảo tăng tỷ lệ sống của ấu trùng tôm ở độ mặn thấp
Vi tảo tăng tỷ lệ sống của ấu trùng tôm ở độ mặn thấp Chiến lược phòng ngừa EHP thông qua kiểm soát môi trường ao nuôi
Chiến lược phòng ngừa EHP thông qua kiểm soát môi trường ao nuôi Một quan điểm tiên phong về di truyền tôm
Một quan điểm tiên phong về di truyền tôm Cách giải quyết những bệnh tôm chính hiện nay
Cách giải quyết những bệnh tôm chính hiện nay Tăng cường miễn dịch trên cá tra bằng cây mắc cỡ
Tăng cường miễn dịch trên cá tra bằng cây mắc cỡ Bacillus amyloliquefaciens - Chiến lược mới kiểm soát mầm bệnh và cải thiện sức khỏe đường ruột
Bacillus amyloliquefaciens - Chiến lược mới kiểm soát mầm bệnh và cải thiện sức khỏe đường ruột 3 HÓA CHẤT XỬ LÝ NƯỚC TRONG MÔ HÌNH NUÔI SIÊU THÂM CANH
3 HÓA CHẤT XỬ LÝ NƯỚC TRONG MÔ HÌNH NUÔI SIÊU THÂM CANH Flavonoid ảnh hưởng đến sức khỏe và hiệu suất của tôm thẻ chân trắng
Flavonoid ảnh hưởng đến sức khỏe và hiệu suất của tôm thẻ chân trắng Sản xuất tôm không sử dụng kháng sinh
Sản xuất tôm không sử dụng kháng sinh Thách thức trong chuyển giao mùa và mùa lạnh đối với tôm nuôi
Thách thức trong chuyển giao mùa và mùa lạnh đối với tôm nuôi Công nghệ Na Uy cho cách canh tác mới
Công nghệ Na Uy cho cách canh tác mới Chủ động giám sát WSSV và AHPND để giảm thiểu tác động tiêu cực đối với nuôi tôm thẻ
Chủ động giám sát WSSV và AHPND để giảm thiểu tác động tiêu cực đối với nuôi tôm thẻ Ảnh hưởng của pH nước lên sinh lý máu và màu sắc của cá Chốt Bông
Ảnh hưởng của pH nước lên sinh lý máu và màu sắc của cá Chốt Bông Xác định mầm bệnh ký sinh trùng trên cá tra (Pangasianodon hypophthalmus) tự nhiên
Xác định mầm bệnh ký sinh trùng trên cá tra (Pangasianodon hypophthalmus) tự nhiên Ảnh hưởng của pH nước lên khả năng nhạy cảm đối với vi khuẩn gây bệnh hoại tử gan tụy cấp trên tôm thẻ
Ảnh hưởng của pH nước lên khả năng nhạy cảm đối với vi khuẩn gây bệnh hoại tử gan tụy cấp trên tôm thẻ Đáp ứng miễn dịch của cá rô phi với chủng Vaccine Streptococcus agalactiae bất hoạt
Đáp ứng miễn dịch của cá rô phi với chủng Vaccine Streptococcus agalactiae bất hoạt Ảnh hưởng Oxytetracycline lên đáp ứng miễn dịch tự nhiên của tôm thẻ cảm nhiễm Vibrio
Ảnh hưởng Oxytetracycline lên đáp ứng miễn dịch tự nhiên của tôm thẻ cảm nhiễm Vibrio Ảnh hưởng của thay đổi độ mặn đến tăng trưởng tôm sú giống
Ảnh hưởng của thay đổi độ mặn đến tăng trưởng tôm sú giống Carbon Dioxide ảnh hưởng đến tăng trưởng và tỉ lệ sống của tôm thẻ chân trắng
Carbon Dioxide ảnh hưởng đến tăng trưởng và tỉ lệ sống của tôm thẻ chân trắng Nhiệt độ ảnh hưởng đến tỉ lệ dị hình của ấu trùng cá chim vây vàng
Nhiệt độ ảnh hưởng đến tỉ lệ dị hình của ấu trùng cá chim vây vàng Đánh giá ảnh hưởng của lá cây màng tang lên khả năng kháng bệnh do vi khuẩn của cá trắm cỏ
Đánh giá ảnh hưởng của lá cây màng tang lên khả năng kháng bệnh do vi khuẩn của cá trắm cỏ Tinh dầu quế ức chế khả năng giao tiếp của vi khuẩn Vibrio
Tinh dầu quế ức chế khả năng giao tiếp của vi khuẩn Vibrio Ảnh hưởng sốc độ mặn trong giai đoạn thả giống tôm sú
Ảnh hưởng sốc độ mặn trong giai đoạn thả giống tôm sú EHP – MỐI ĐE DỌA CỦA NGÀNH TÔM VIỆT
EHP – MỐI ĐE DỌA CỦA NGÀNH TÔM VIỆT TÔM THẺ CHÂN TRẮNG TĂNG TRƯỞNG TỐT TRONG AO NUÔI NƯỚC NGỌT VÀO MÙA ĐÔNG
TÔM THẺ CHÂN TRẮNG TĂNG TRƯỞNG TỐT TRONG AO NUÔI NƯỚC NGỌT VÀO MÙA ĐÔNG SODIUM BICARBONATE - THUỐC GÂY MÊ AN TOÀN CHO CÁ ĐIÊU HỒNG
SODIUM BICARBONATE - THUỐC GÂY MÊ AN TOÀN CHO CÁ ĐIÊU HỒNG Cải thiện hiệu quả khi nuôi tôm ở độ mặn thấp
Cải thiện hiệu quả khi nuôi tôm ở độ mặn thấp Phát triển Monoglyceride nhằm chống lại AHPND
Phát triển Monoglyceride nhằm chống lại AHPND Tinh dầu húng quế có thể thúc đẩy tăng trưởng cá Rô phi
Tinh dầu húng quế có thể thúc đẩy tăng trưởng cá Rô phi Chiết xuất từ sâm đại hành - Tiềm năng về hiệu suất tăng trưởng của tôm thẻ
Chiết xuất từ sâm đại hành - Tiềm năng về hiệu suất tăng trưởng của tôm thẻ Một bước đột phá để nhân giống cá rô phi kháng Streptococcus
Một bước đột phá để nhân giống cá rô phi kháng Streptococcus Xử lý tình hình cá chết trên sông La Ngà
Xử lý tình hình cá chết trên sông La Ngà Thảo dược Physalis angulata đối với bệnh phân trắng trên tôm thẻ chân trắng
Thảo dược Physalis angulata đối với bệnh phân trắng trên tôm thẻ chân trắng Xử lý các khí độc ao tôm
Xử lý các khí độc ao tôm Tiêu chuẩn kỹ thuật lựa chọn tôm giống chất lượng
Tiêu chuẩn kỹ thuật lựa chọn tôm giống chất lượng Chủng vi khuẩn mới phân giải ammonia và nitrite trong ao nuôi tôm
Chủng vi khuẩn mới phân giải ammonia và nitrite trong ao nuôi tôm Yếu tố giảm nguy cơ nhiễm bệnh đốm trắng trên tôm nuôi
Yếu tố giảm nguy cơ nhiễm bệnh đốm trắng trên tôm nuôi Thêm một loài tôm tiềm năng cho nuôi trồng thủy sản
Thêm một loài tôm tiềm năng cho nuôi trồng thủy sản BACILLUS SUBTILIS - VACCINE MỚI CHO CÁ RÔ PHI
BACILLUS SUBTILIS - VACCINE MỚI CHO CÁ RÔ PHI Lưu ý khi sử dụng sầu đâu trong hệ thống biofloc
Lưu ý khi sử dụng sầu đâu trong hệ thống biofloc Chống Lại Các Bệnh Trên Tôm Từ Probiotics
Chống Lại Các Bệnh Trên Tôm Từ Probiotics Nguyên Nhân Và Biện Pháp Phòng Trị Chủng Vi Khuẩn Edwardsiella
Nguyên Nhân Và Biện Pháp Phòng Trị Chủng Vi Khuẩn Edwardsiella GIẢI PHÁP TỰ NHIÊN CHỐNG LẠI VIBRIO TRONG NUÔI TÔM
GIẢI PHÁP TỰ NHIÊN CHỐNG LẠI VIBRIO TRONG NUÔI TÔM LÀM THẾ NÀO ĐỂ KIỂM SOÁT CÁC BỆNH LIÊN QUAN ĐẾN GAN TỤY CỦA TÔM THẺ
LÀM THẾ NÀO ĐỂ KIỂM SOÁT CÁC BỆNH LIÊN QUAN ĐẾN GAN TỤY CỦA TÔM THẺ CHO CÁ ĂN TỎI, CHỮA ĐƯỢC 2 BỆNH, THU HÀNG TRĂM TRIỆU ĐỒNG
CHO CÁ ĂN TỎI, CHỮA ĐƯỢC 2 BỆNH, THU HÀNG TRĂM TRIỆU ĐỒNG NUÔI TÔM SÚ AN TOÀN, KHÔNG KHÁNG SINH: LỢI ÍCH THẤY RÕ
NUÔI TÔM SÚ AN TOÀN, KHÔNG KHÁNG SINH: LỢI ÍCH THẤY RÕ BỆNH MỚI DO VIRUS (SHIV) GÂY RA TRÊN TÔM THẺ CHÂN TRẮNG Ở TRUNG QUỐC
BỆNH MỚI DO VIRUS (SHIV) GÂY RA TRÊN TÔM THẺ CHÂN TRẮNG Ở TRUNG QUỐC THỬ NGHIỆM PCR CÁC MẪU ĐƠN MÔ Ở TÔM CÓ THỂ DẪN ĐẾN DỮ LIỆU GÂY HIỂU LẦM
THỬ NGHIỆM PCR CÁC MẪU ĐƠN MÔ Ở TÔM CÓ THỂ DẪN ĐẾN DỮ LIỆU GÂY HIỂU LẦM VAI TRÒ CỦA BỔ SUNG NƯỚC ĐIỆN GIẢI CHO TÔM
VAI TRÒ CỦA BỔ SUNG NƯỚC ĐIỆN GIẢI CHO TÔM LOẠI BỎ CHẤT THẢI TRONG HỆ THỐNG RAS
LOẠI BỎ CHẤT THẢI TRONG HỆ THỐNG RAS LẶN BẮT SÒ LÁNG “QUẬY” ĐỤC NƯỚC VỊNH XUÂN ĐÀI, GÂY HẠI TÔM HÙM NUÔI
LẶN BẮT SÒ LÁNG “QUẬY” ĐỤC NƯỚC VỊNH XUÂN ĐÀI, GÂY HẠI TÔM HÙM NUÔI CHIẾT XUẤT TẢO BIỂN – HƯỚNG TIẾP CẬN MỚI CHO SỨC KHỎE ĐỘNG VẬT THỦY SẢN
CHIẾT XUẤT TẢO BIỂN – HƯỚNG TIẾP CẬN MỚI CHO SỨC KHỎE ĐỘNG VẬT THỦY SẢN CHÚ TRỌNG PHÒNG CHỐNG DỊCH BỆNH CHO TÔM
CHÚ TRỌNG PHÒNG CHỐNG DỊCH BỆNH CHO TÔM LỌC SINH HỌC VỚI RONG CÂU TRONG NUÔI TÔM THẺ CHÂN TRẮNG
LỌC SINH HỌC VỚI RONG CÂU TRONG NUÔI TÔM THẺ CHÂN TRẮNG ẢNH HƯỞNG CỦA ĐỘ MẶN ĐẾN 3 PROBIOTICS TRONG NUÔI TÔM
ẢNH HƯỞNG CỦA ĐỘ MẶN ĐẾN 3 PROBIOTICS TRONG NUÔI TÔM GIẢI PHÁP PHÁT TRIỂN THỨC ĂN TRONG NUÔI TRỒNG THUỶ SẢN
GIẢI PHÁP PHÁT TRIỂN THỨC ĂN TRONG NUÔI TRỒNG THUỶ SẢN LỘC HÀ SẴN SÀNG PHƯƠNG ÁN
LỘC HÀ SẴN SÀNG PHƯƠNG ÁN HIỆU QUẢ TỪ NUÔI TÔM ỨNG DỤNG KỸ THUẬT CAO
HIỆU QUẢ TỪ NUÔI TÔM ỨNG DỤNG KỸ THUẬT CAO VIBRIO TRONG ĐƯỜNG RUỘT TÔM THÁCH THỨC VÀ CHIẾN LƯỢC KIỂM SOÁT
VIBRIO TRONG ĐƯỜNG RUỘT TÔM THÁCH THỨC VÀ CHIẾN LƯỢC KIỂM SOÁT VITAMIN, CHẤT DINH DƯỠNG VÀ THẢO DƯỢC THƯỜNG ĐƯỢC SỬ DỤNG TRONG NUÔI TÔM
VITAMIN, CHẤT DINH DƯỠNG VÀ THẢO DƯỢC THƯỜNG ĐƯỢC SỬ DỤNG TRONG NUÔI TÔM HIỆU ỨNG MÙA MƯA TRÊN AO NUÔI TÔM
HIỆU ỨNG MÙA MƯA TRÊN AO NUÔI TÔM POLYSACCHARIDES HIỆU QUẢ MANG LẠI LÀ GÌ?
POLYSACCHARIDES HIỆU QUẢ MANG LẠI LÀ GÌ? ĐỘC TỐ MELAMINE VÀ HỘI CHỨNG ĐẦU LỚN TRÊN TÔM
ĐỘC TỐ MELAMINE VÀ HỘI CHỨNG ĐẦU LỚN TRÊN TÔM HIỆU QUẢ MANG LẠI TỪ CỦ RIỀNG CHO NGÀNH NUÔI TÔM
HIỆU QUẢ MANG LẠI TỪ CỦ RIỀNG CHO NGÀNH NUÔI TÔM MICROSPORIDIANS - VẤN ĐỀ LỚN TRONG NGÀNH NUÔI TRỒNG THỦY SẢN
MICROSPORIDIANS - VẤN ĐỀ LỚN TRONG NGÀNH NUÔI TRỒNG THỦY SẢN KHOÁNG CHẤT TRONG NUÔI TÔM - NHỮNG ĐIỀU CẦN BIẾT
KHOÁNG CHẤT TRONG NUÔI TÔM - NHỮNG ĐIỀU CẦN BIẾT VITAMIN C VÀ VITAMIN TỔNG HỢP - NHỮNG GIÁ TRỊ CẦN ĐƯỢC HIỂU RÕ HƠN
VITAMIN C VÀ VITAMIN TỔNG HỢP - NHỮNG GIÁ TRỊ CẦN ĐƯỢC HIỂU RÕ HƠN ACID HỮU CƠ KẾT HỢP TINH DẦU - BƯỚC ĐỘT PHÁ TRONG NUÔI TRỒNG THỦY SẢN
ACID HỮU CƠ KẾT HỢP TINH DẦU - BƯỚC ĐỘT PHÁ TRONG NUÔI TRỒNG THỦY SẢN KHOÁNG CHẤT ĐA VI LƯỢNG CẦN THIẾT TRONG NUÔI TÔM
KHOÁNG CHẤT ĐA VI LƯỢNG CẦN THIẾT TRONG NUÔI TÔM CHẤT HỮU CƠ, BÙN ĐÁY - NGUYÊN NHÂN GÂY RA NHIỀU XÁO TRỘN KHÔNG MONG MUỐN TRONG AO
CHẤT HỮU CƠ, BÙN ĐÁY - NGUYÊN NHÂN GÂY RA NHIỀU XÁO TRỘN KHÔNG MONG MUỐN TRONG AO NUCLEOTIDES - MỐI LIÊN KẾT CÒN THIẾU TRONG DINH DƯỠNG ĐỘNG VẬT HIỆN ĐẠI
NUCLEOTIDES - MỐI LIÊN KẾT CÒN THIẾU TRONG DINH DƯỠNG ĐỘNG VẬT HIỆN ĐẠI PHỤ GIA TẢO BIỂN GIÚP TÔM HỒI PHỤC SAU SỐC LẠNH
PHỤ GIA TẢO BIỂN GIÚP TÔM HỒI PHỤC SAU SỐC LẠNH BỆNH ĐỐM TRẮNG TRÊN TÔM: LÀM THẾ NÀO ĐỂ HỖ TRỢ NGƯỜI NUÔI TÔM QUẢNG CANH?
BỆNH ĐỐM TRẮNG TRÊN TÔM: LÀM THẾ NÀO ĐỂ HỖ TRỢ NGƯỜI NUÔI TÔM QUẢNG CANH?






